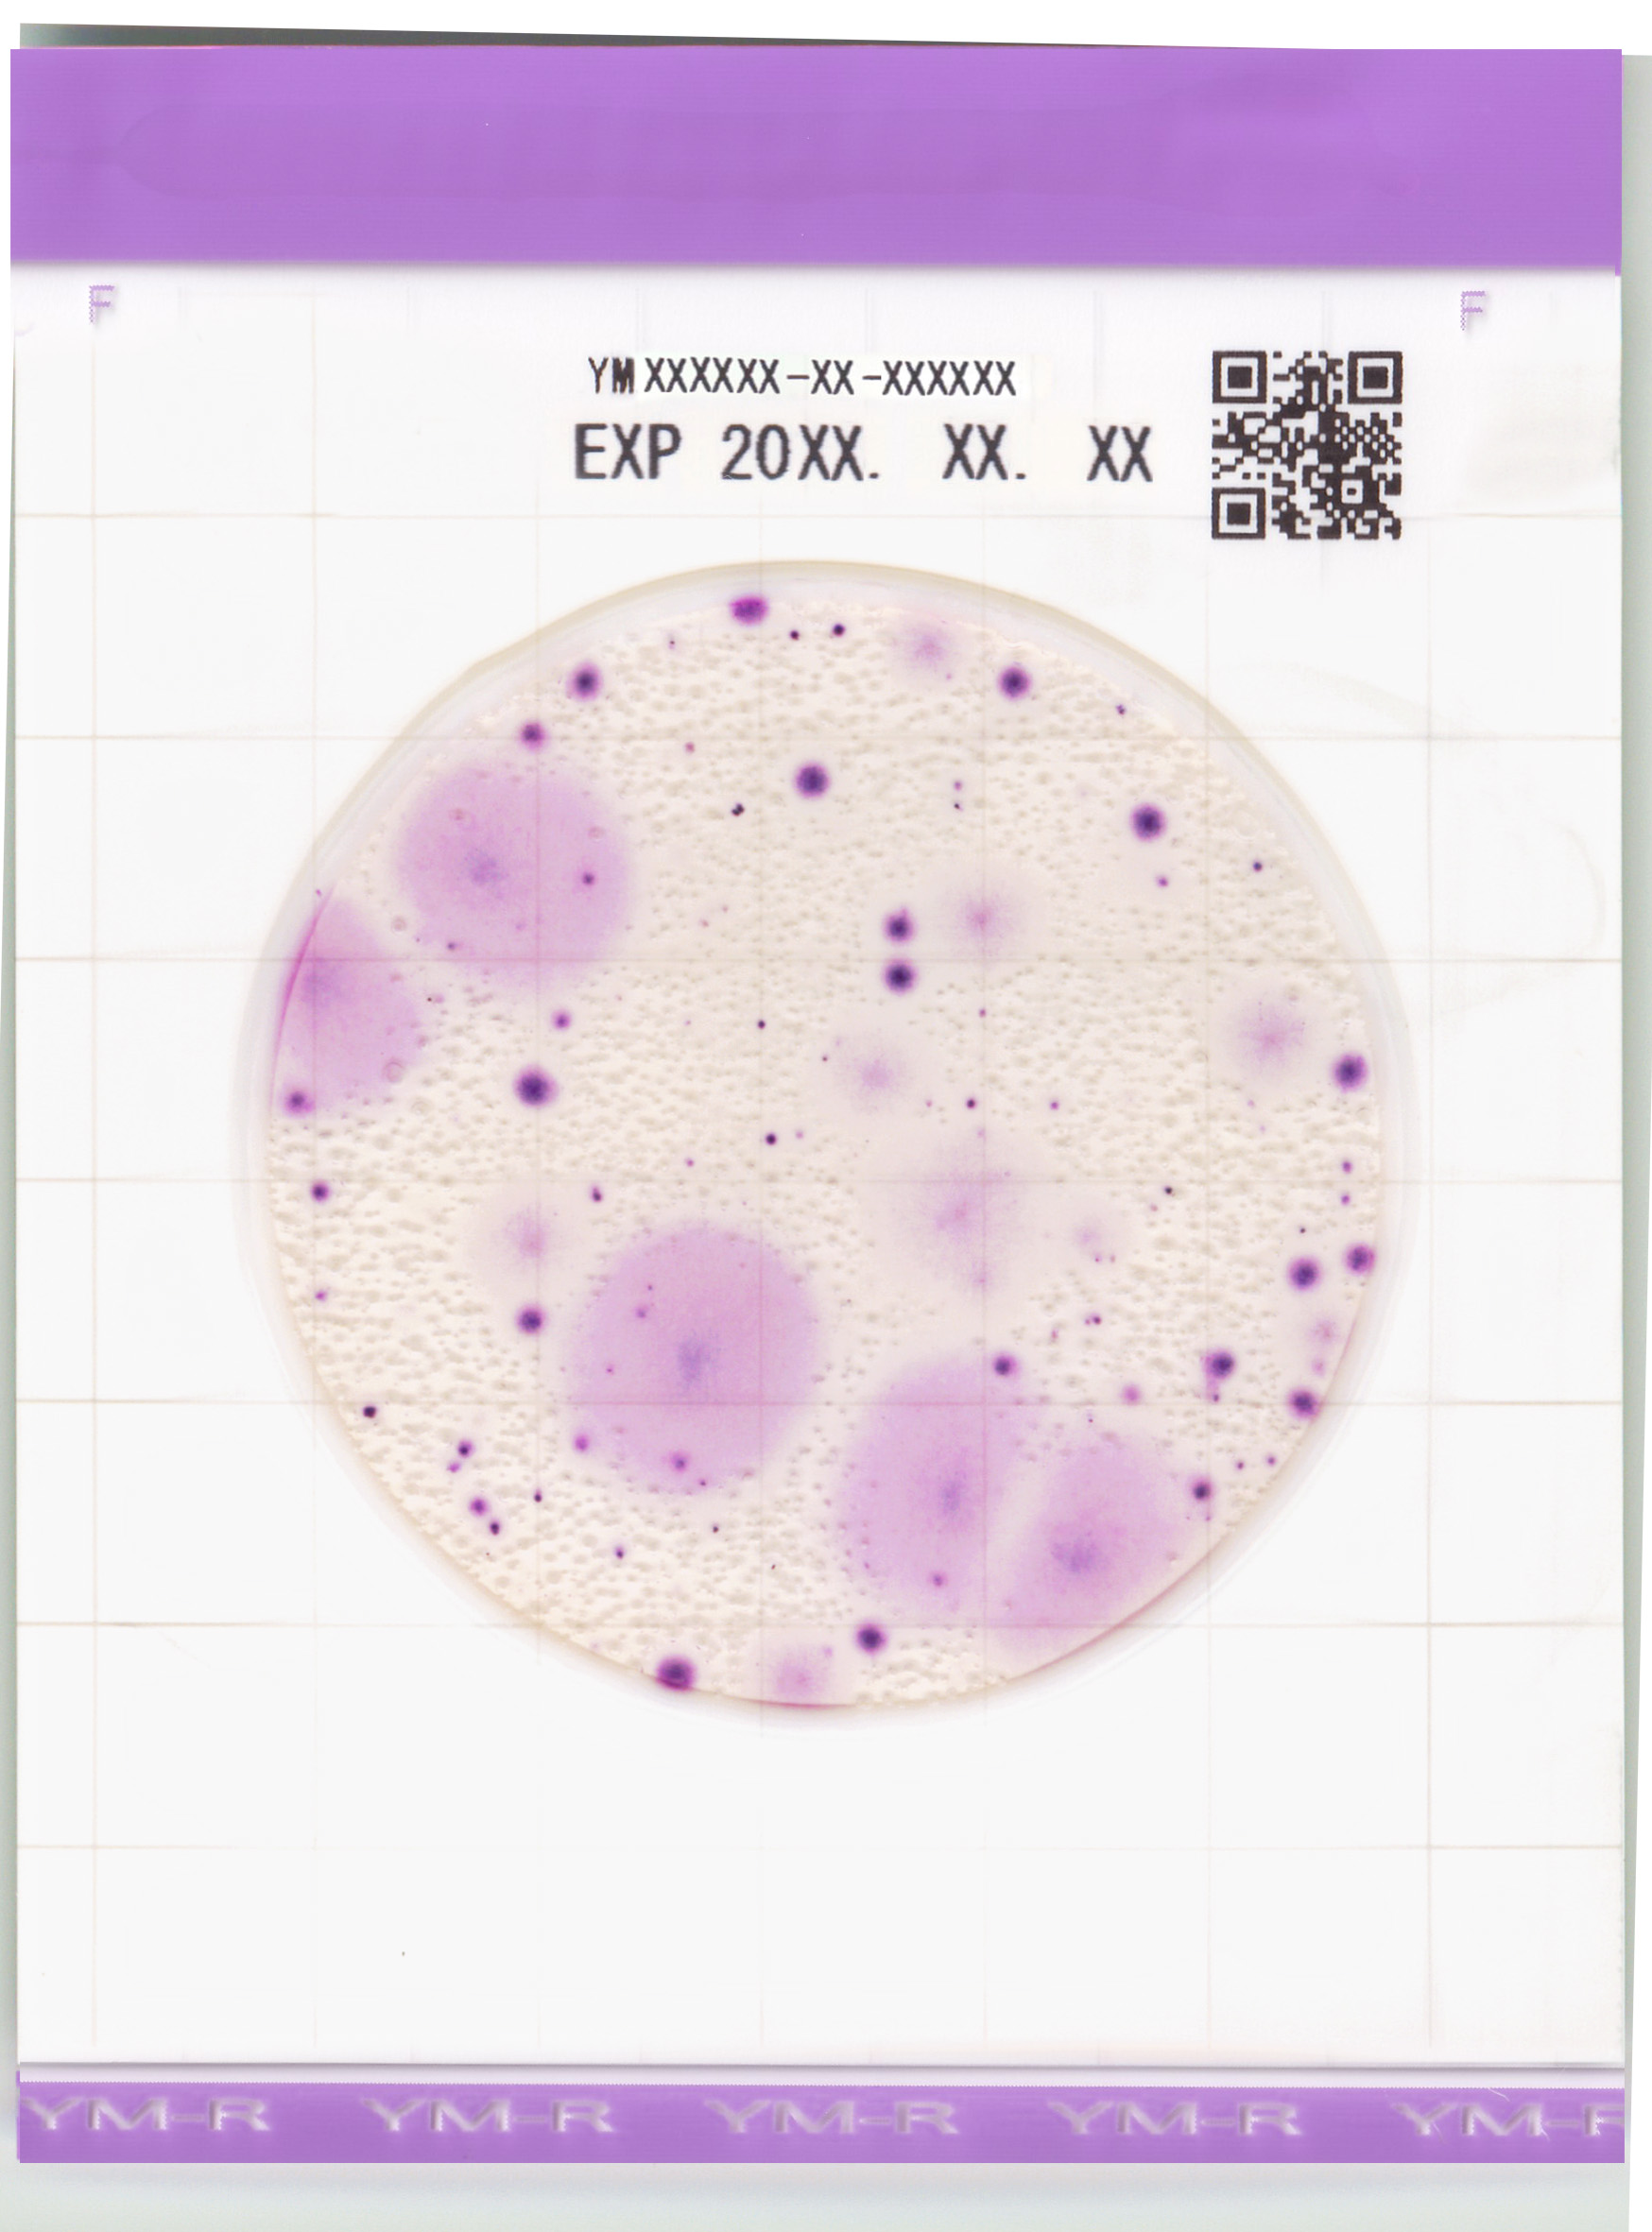

About Kikkoman Biochemifa Company
Kikkoman Biochemifa Company, a subsidiary of the Kikkoman Group, is dedicated to advancing food safety, hygiene monitoring, and life science research. Building on Kikkoman’s long-standing tradition of trust and innovation, we develop reliable testing solutions that enhance quality assurance across industries. Our flagship products include the ATP Test (Kikkoman A3), a total adenylate hygiene monitoring system, and the Easy Plate series, ready-to-use microbiological media that simplify microbial testing. Through science-driven innovation and sustainable practices, Kikkoman Biochemifa empowers professionals in food manufacturing, healthcare, and research to make informed decisions that protect consumers and promote a cleaner, safer world.
About Kikkoman Biochemifa Company
Kikkoman Biochemifa Company, a subsidiary of the Kikkoman Group, is dedicated to advancing food safety, hygiene monitoring, and life science research. Building on Kikkoman’s long-standing tradition of trust and innovation, we develop reliable testing solutions that enhance quality assurance across industries. Our flagship products include the ATP Test (Kikkoman A3), a total adenylate hygiene monitoring system, and the Easy Plate series, ready-to-use microbiological media that simplify microbial testing. Through science-driven innovation and sustainable practices, Kikkoman Biochemifa empowers professionals in food manufacturing, healthcare, and research to make informed decisions that protect consumers and promote a cleaner, safer world.
Company Resources
The ATP Test (Kikkoman A3) is an advanced hygiene monitoring system that detects ATP, ADP, and AMP, providing rapid, accurate, and comprehensive cleanliness verification for food, healthcare, and sanitation industries.
Easy Plate YM-R is a rapid, ready-to-use medium for detecting and quantifying yeast and mold, providing precise results within 48 hours to support effective mold assessment and contamination control.
The ATP Test (Kikkoman A3) is listed in the ISSA Clean Standards, supporting “Clean, Measure, Monitor” practices by providing objective, data-driven cleanliness verification for schools and institutional facilities.
Lumitester Smart and LuciPac A3 were featured in ISSA Cleaning for Health workshop, demonstrating how ATP testing enhances infection prevention, surface cleanliness verification, and facility readiness for GBAC STAR accreditation.
To implement the ATP Test (Kikkoman A3), define test points, establish sampling rules, and set pass/fail limits using manufacturer references, 80th percentile data, or user-defined baseline values.
Kikkoman Biochemifa’s ATP Test (Kikkoman A3) Wins ISSA Excellence Awards 2025 – Service & Technology
The ATP Test (Kikkoman A3) won the 2025 ISSA Excellence Award for Service & Technology, recognizing innovation that enhances performance, safety, and sustainability in commercial, institutional, and residential cleaning.